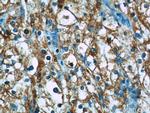
BMP7 Antibody in Immunohistochemistry (Paraffin) (IHC (P))
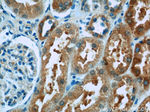
BMP7 Antibody in Immunohistochemistry (Paraffin) (IHC (P))

Search
Proteintech
BMP7 Polyclonal Antibody
{{$productOrderCtrl.translations['antibody.pdp.commerceCard.promotion.promotions']}}
{{$productOrderCtrl.translations['antibody.pdp.commerceCard.promotion.viewpromo']}}
{{$productOrderCtrl.translations['antibody.pdp.commerceCard.promotion.promocode']}}: {{promo.promoCode}} {{promo.promoTitle}} {{promo.promoDescription}}. {{$productOrderCtrl.translations['antibody.pdp.commerceCard.promotion.learnmore']}}
产品信息
12221-1-AP
种属反应
已发表种属
宿主/亚型
分类
类型
抗原
偶联物
形式
浓度
规格
纯化类型
保存液
内含物
保存条件
运输条件
产品详细信息
Immunogen sequence: FMLDLYNAM AVEEGGGPGG QGFSYPYKAV FSTQGPPLAS LQDSHFLTDA DMVMSFVNLV EHDKEFFHPR YHHREFRFDL SKIPEGEAVT AAEFRIYKDY IRERFDNETF RISVYQVLQE HLGRESDLFL LDSRTLWASE EGWLVFDITA TSNHWVVNPR HNLGLQLSVE TLDGQSINPK LAGLIGRHGP QNKQPFMVAF FKATEVHFRS IRSTGSKQRS QNRSKTPKNQ EALRMANVAE NSSSDQRQAC KKHELYVSFR DLGWQDWIIA PEGYAAYYCE GECAFPLNSY MNATNHAIVQ TLVHFINPET VPKPCCAPTQ LNAISVLYFD DSSNVILKKY RNMVVRACGC H (82-431 aa encoded by BC008584)
靶标信息
The bone morphogenetic proteins (BMPs) are a family of secreted signaling molecules that can induce ectopic bone growth. Many BMPs are part of the transforming growth factor-beta (TGFB) superfamily. BMPs were originally identified by an ability of demineralized bone extract to induce endochondral osteogenesis in vivo in an extra skeletal site. Based on its expression early in embryogenesis, BMP7 has a proposed role in early development. In addition, the fact that BMP7 is closely related to BMP5 and BMP6 has lead to speculation of possible bone inductive activity.
仅用于科研。不用于诊断过程。未经明确授权不得转售。
生物信息学
蛋白别名: BMP; BMP-7; BMP7; Bone morphogenetic protein; Bone morphogenetic protein 7; OP-1; Osteogenic protein 1; RP11-560A15.5; unnamed protein product
基因别名: Bmp-7; BMP7; OP-1; OP1
UniProt ID: (Human) P18075, (Mouse) P23359
Entrez Gene ID: (Human) 655, (Mouse) 12162